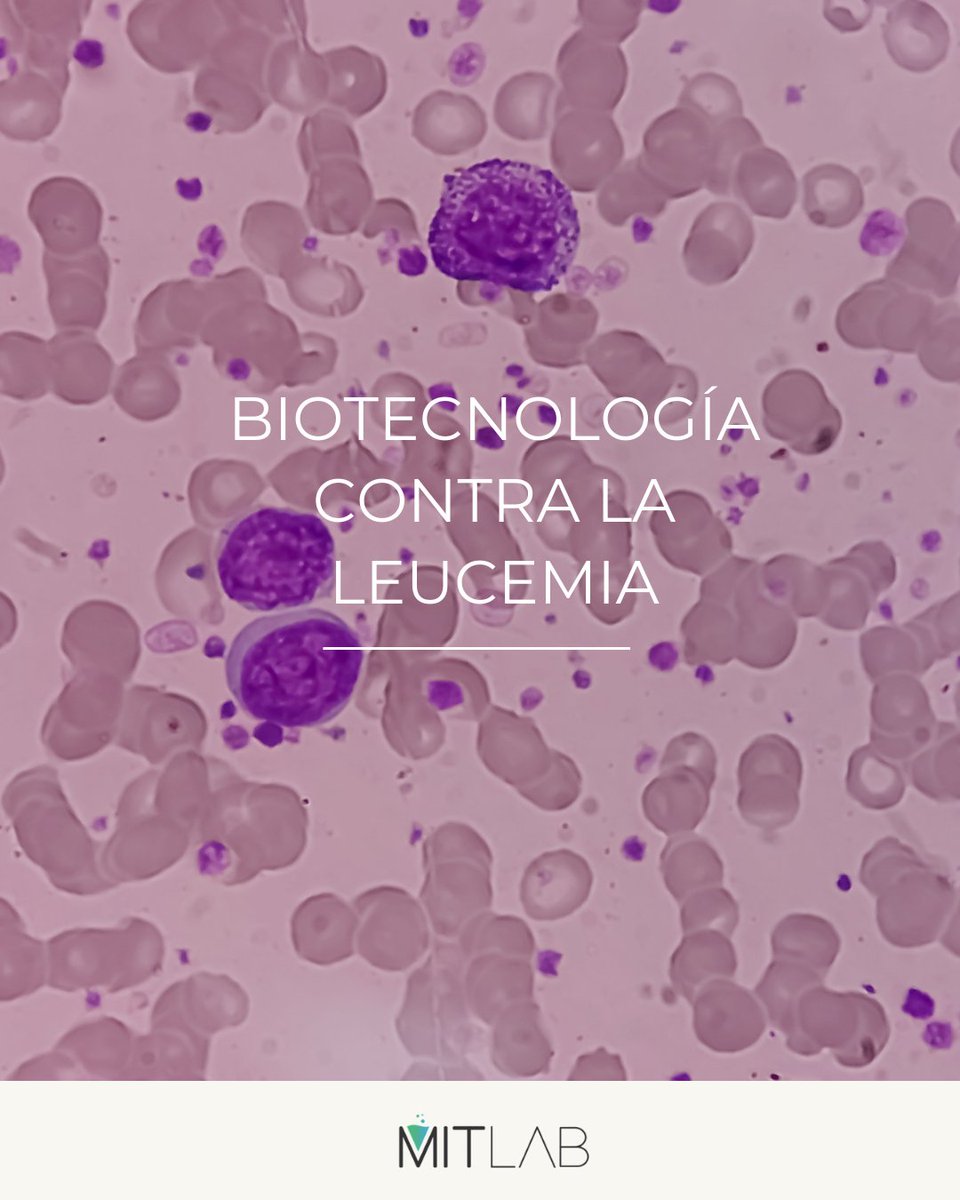
MITLAB tweet media

Vuelve el "Seminario del Mes" !GRATIS! 💥
Parte I: Estudios de estabilidad en medicamentos: degradación forzada
No dejes pasar esta oportunidad única de formación en MITLAB.🚀
➕ Más información en nuestra web: formate.mit-lab.com/producto/estud…
#MITLAB #Ciencia #Laboratorio #Formación


Español